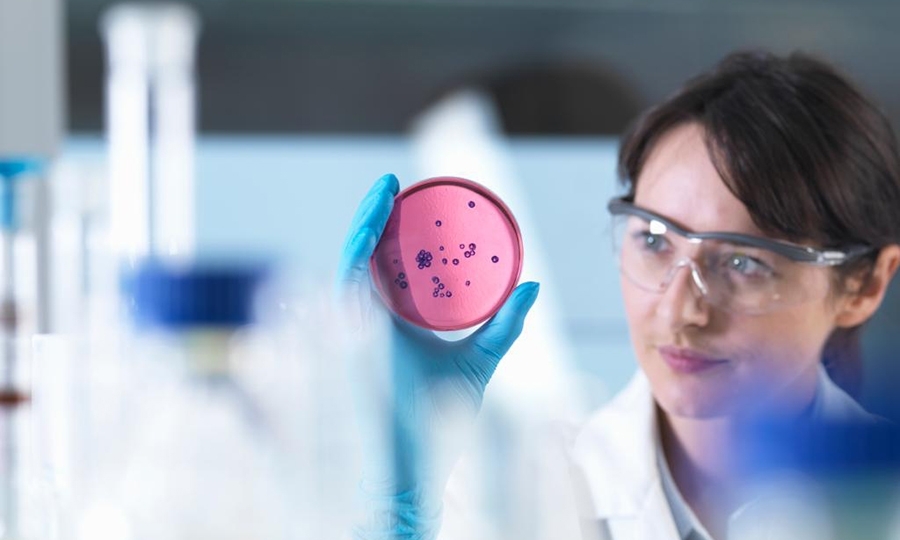

Οι τελευταίοι μήνες του χρόνου αποτελούν πάντα μια καλή αφορμή για να ξαναδούμε και να αναθεωρήσουμε τις προσωπικές μας συνήθειες. Εάν ανήκετε στην κατηγορία των καπνιστών συμβατικού τσιγάρου, τα όσα προέκυψαν από το Open Science webinar, που διοργάνωσε για δεύτερη φορά η Philip Morris International (PMI), ίσως να σας ενδιαφέρουν.
Παρακάτω ένα σύντομο “crash-test”, όπως το διαμορφώσαμε με βάση τις θέσεις των ειδικών επιστημόνων της PMI:
Αερόλυμα προϊόντος θέρμανσης του καπνού vs. Καπνού του τσιγάρου
Όπως εξήγησε ο Dr. Markus Nordlund, Lead Scientific & Medical Affairs της PMI, ο καπνός που παράγεται από την καύση του συμβατικού τσιγάρου περιέχει πλήθος από χημικά αέρια, υγρά σταγονίδια και στερεά σωματίδια - συνήθως υποπροϊόντα της καύσης του καπνού με βάση τoν άνθρακα, με τοξικές και βλαπτικές συνέπειες για την υγεία του καπνιστή. Όσο για το αερόλυμα που παράγεται από το IQOS, λόγω της απουσίας καύσης, αποτελείται από αέρια μάζα και υγρά σταγονίδια μόνο. Επομένως, έχουμε να κάνουμε με την πλήρη απουσία των στερεών σωματιδίων που ανιχνεύονται στο συμβατικό τσιγάρο.

Καύση του καπνού vs. πλήρους απουσίας καύσης
O Dr. Tom McGrath, Global Head of Professional Channels της εταιρείας, τόνισε την σημαντικότητα της απουσίας καύσης αναλύοντας ως εξής τις διαφορές: Στο συμβατικό τσιγάρο, όπου έχουμε καύση του καπνού, αναπτύσσονται υψηλές θερμοκρασίες που μπορούν να φτάσουν έως και τους 900 βαθμούς Κελσίου. Επομένως, έχουμε τον παραγόμενο καπνό που περιέχει υψηλές συγκεντρώσεις επιβλαβών χημικών υποπροϊόντων της καύσης και ανιχνεύονται κυρίως ως στερεά σωματίδια. Στο σύστημα θέρμανσης καπνού, αντίθετα, οι θερμοκρασίες που αναπτύσσονται διατηρούνται σε χαμηλά επίπεδα έως και 350 βαθμούς Κελσίου, θερμοκρασίες όπου οι ράβδοι καπνού εκλύουν αέρια μέσω της διαδικασίας της πυρόλυσης και με παντελή απουσία καύσης. Μέρος της χημικής σύστασης του αερολύματος σε αυτές τις θερμοκρασίες θα υγροποιηθεί, με τελικό αποτέλεσμα το παραγόμενο αερόλυμα να αποτελείται από αέρια μάζα και υγρά σταγονίδια.
Χημική σύσταση IQOS vs. συμβατικού τσιγάρου
Τις διαφορές στη χημική σύσταση του αερολύματος και του καπνού εξήγησε ο Mark Bentley, Manager Project Management & Knowledge Integration. Με βάση όσα είπε, ο καπνός του συμβατικού τσιγάρου, από τη μία, περιέχει πάνω από 6.000 χημικές ουσίες, αρκετές από τις οποίες έχουν χαρακτηριστεί ως βλαβερές ή δυνητικά βλαβερές από διεθνείς οργανισμούς υγείας, όπως η λίστα με τις 93 χημικές ουσίες την οποία έχει καταρτίσει ο Οργανισμός Τροφίμων και Φαρμάκων των ΗΠΑ (FDA 93). Από την άλλη πλευρά, στο αερόλυμα του IQOS έχουν αναγνωριστεί και αξιολογηθεί 532 χημικές ουσίες, εκ των οποίων με βάση την ίδια λίστα FDA 93, οι συγκεντρώσεις των βλαβερών ή δυνητικά βλαβερών ουσιών μειώνονται από 90% έως και 95% σε σύγκριση με την ανιχνεύσιμη συγκέντρωσή τους στον καπνό του καιόμενου τσιγάρου αναφοράς, δηλαδή του τσιγάρου που χρησιμοποιείται στην επιστημονική έρευνα.

H επίδραση στον αέρα των εσωτερικών χώρων του αερολύματος του IQOS vs. του καπνού του συμβατικού τσιγάρου
Όσον αφορά στην ποιότητα του αέρα στο χώρο μας η Dr. Catherine Goujon, Manager Chemistry Research, ήταν ξεκάθαρη: το αερόλυμα που παράγει το προϊόν θέρμανσης του καπνού έχει λιγότερο έντονη μυρωδιά και διαλύεται γρήγορα. H μυρωδιά που μένει στα χέρια, τα μαλλιά, τα ρούχα και τον χώρο μας είναι αισθητά μειωμένη, σε σχέση με τη μυρωδιά του συμβατικού τσιγάρου που δεν είναι διόλου ευχάριστη.
Εάν ανήκετε στην κατηγορία εκείνων που αντιμετωπίζουν με σκεπτικισμό τα παραπάνω αποτελέσματα καθώς προκύπτουν από το τμήμα ‘Ερευνας και Ανάπτυξης της ίδιας της εταιρείας, ο Dr. Maurice Smith, Senior Scientific Advisor είναι κατάλληλος για να απαντήσει. Στο πλαίσιο του webinar, επικαλέστηκε δημοσιεύσεις από ανεξάρτητους φορείς υγείας που επιβεβαιώνουν τα αποτελέσματα, όσον αφορά στη χημική σύσταση του αερολύματος καθώς και τη χαμηλή συγκέντρωση σε βλαβερές/δυνητικά βλαβερές χημικές ουσίες που ανιχνεύονται σε σύγκριση με το συμβατικό τσιγάρο.
Μεταξύ των ανακοινώσεων υπάρχει, πλέον – όπως είπε - και η πρόσφατη αδειοδότηση του IQOS ως «Προϊόν Καπνού Διαφοροποιημένου Κινδύνου» από τον Οργανισμό Τροφίμων και Φαρμάκων των ΗΠΑ, όπου χαρακτηριστικά αναφέρεται πως «το IQOS είναι ένα προϊόν ξεκάθαρα διαφοροποιημένο από τα συμβατικά τσιγάρα, το οποίο θερμαίνει αλλά δεν καίει τον καπνό. Το γεγονός αυτό μειώνει σημαντικά την παραγωγή επιβλαβών και δυνητικά επιβλαβών χημικών ουσιών και επιστημονικές μελέτες έχουν δείξει ότι η πλήρης μετάβαση από το συμβατικό τσιγάρο στο σύστημα IQOS μειώνει την έκθεση του οργανισμού σε επιβλαβείς ή δυνητικά επιβλαβείς χημικές ουσίες». Η ίδια ανακοίνωση καταλήγει ότι η απόφαση αυτή του Οργανισμού είναι κατάλληλη για την προαγωγή της δημόσιας υγείας και αναμένεται να ωφελήσει την υγεία του πληθυσμού στο σύνολό του.






























